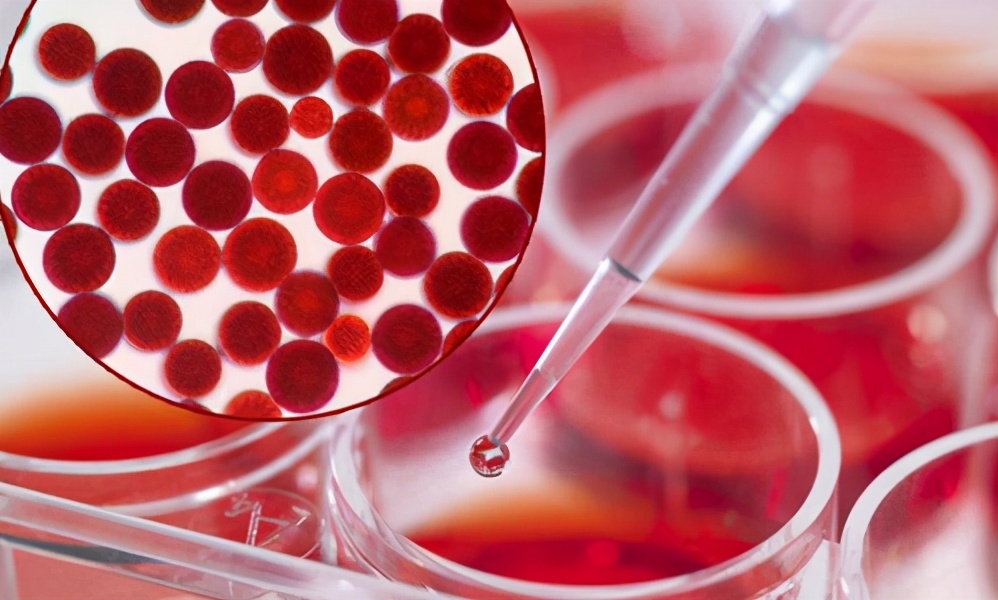
虾青素精华液的功效与作用禁忌,吃虾青素的十大禁忌

哈喽,小伙伴们,今天也是成分*党**颐莲哦~
爱美的小仙女一定对“虾青素”不陌生吧,虾青素又名雨生红藻提取物,有着地表最强抗氧化物质的美称。

虾青素也分为2种,一种是人工合成,一种是天然提取。目前市面上大部分使用的是自然提取,虾青素属于油溶性物质具备更好的与皮肤相容的特性,分子量的问题也能通过载体进行解决虽然本身分子量也不大仅有596.841g/mol。

在护肤领域,虾青素属于抗氧化物质具备的功效还是比较多的,例如:清除自由基,可以抑制UVA诱导的基质损伤,具备一定的防晒作用等等~
为何大家都爱虾青素护肤?

1、具有强抗氧化性:我们的肌肤每天都在面临各种辐射跟氧化,如果不做到很好的防护措施的话,那就很容易导致肌肤出现老化的情况。这个时候使用含有虾青素的护肤品,来帮助延缓我们的衰老,保持肌肤活力~

2、增加肌肤弹性:当肌肤老化以后,皮肤就会变得特别松弛,整个人的状态看上去会非常差,而虾青素可以帮助改善皮肤松弛和缺乏弹性等方面的问题来。

3、改善毛孔粗大:可能很多人的毛孔或多或少都会存在一点问题,并不是很多人所讲的零瑕疵皮肤。而虾青素则对收缩毛孔有很好的效果,肌肤状态好到爆哦~
但是却不知道家虾青素对于我们的护肤来讲,究竟会起到一些什么样的功效与作用,所以,下面就来为大家主要介绍一下虾青素护肤品怎么用最好!
虾青素护肤品使用禁忌

服用虾青素的同时不要吃富含维生素C的东西,例如橙子,因为维生素C会还原虾青素,使之失去原有的功效。虾青素能够影响人体内的酸碱平衡,所以这也意味着尿酸高的人不能服用虾青素,大家一定要注意了。
虾青素精华是否可以白天是使用?

虾青素不管是白天跟晚上都是可以用的,如果想让肌肤得到一个延缓衰老,增强自身抗氧化能力的效果,那使用虾青素是再好不过的,一般说来建议晚上用,因为晚上肌肤的修复能力会好一点,但如果你一定要选择白天用也可以,但一定要做好防晒工作,这样才能够很好的避免因为别的原因而导致黑色素沉淀~

好像在不久前,突然一阵风,护肤界都在鼓吹“虾青素”,每一个想变美的人,不是在虾青素的路上,就是已经在使用虾青素。话说,你有没有被种草呢?